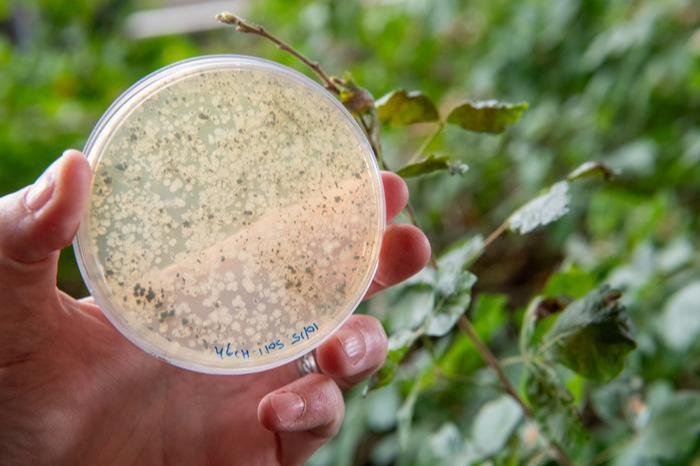
10418_lowres4_649095_crop.jpg

How do microbiomes influence the study of life?
Researchers from the awardwinning One Health Microbiome Center reveal how holobiont biology underpins a holistic understanding of how life’s forms and functions, from human disease to agricultural output, depend upon the relationships between microbes and hosts.
Microorganisms — bacteria, viruses and other tiny life forms — may drive biological variation in visible life as much, if not more, than genetic mutations, creating new lineages and even new species of animals and plants, according to Seth Bordenstein, director of Penn State’s One Health Microbiome Center, professor of biology and entomology, and the Dorothy Foehr Huck and J. Lloyd Huck Endowed Chair in Microbiome Sciences.
Bordenstein and 21 other scientists from around the world published a paper in the leading journal Science, summarizing research that they said drives a deeper understanding of biological variation by uniting life’s seen and unseen realms.
The paper comes as the One Health Microbiome Center at Penn State is named by Applied MIcrobiology International as this year’s winner of the WH Pierce Global Impact in Microbiology Prize 2024.
Newly described concept
The authors explained that this newly described concept — holobiont biology — underpins a multidisciplinary and holistic understanding of how life’s forms and functions, from human disease to agricultural output, depend upon the relationships between microorganisms and their hosts. Penn State News spoke with Bordenstein about the paper and the emerging field of holobiont biology.
The authors explained that this newly described concept — holobiont biology — underpins a multidisciplinary and holistic understanding of how life’s forms and functions, from human disease to agricultural output, depend upon the relationships between microorganisms and their hosts.
READ MORE: Winners of Applied Microbiology International Horizon Awards 2024 announced
READ MORE: Coral reef microbes point to new way to assess ecosystem health
Penn State News spoke with Bordenstein about the paper and the emerging field of holobiont biology.
Q: In simple terms, what is evolution? Why do organisms vary in traits?
The longstanding definition of evolution is the process by which living things change over time by gradually mutating and adapting to their environments. This happens often through a process known as natural selection, where traits that help an organism survive and reproduce are passed on to future generations, while less useful traits gradually disappear.
Historically, we’ve looked at the timescale for evolution as happening over many generations, with these small changes eventually leading to the development of new traits and even new species. Now, when it comes to incorporating the microbiome, the collection of all microbes in and on a host, into this discussion, the timescale and magnitude of biological change becomes more interesting and complex.
Q: What can this new paper tell us about what has been overlooked in the study of life?
Traditionally, biologists have studied visible and invisible life in silos, which has caused our concepts of life to separate. Many scientists were settled in their ways of thinking of microbes as background noise, or transient contaminants without major impact on host life. Yet microbial cells in and on the human body can actually outnumber human cells.
What we’re learning today and over the past decade, is that that sometimes microbes explain more biological trait variation in organisms than the genes do. This is the case, for instance, with the likelihood of human colon cancer, cholesterol levels, and body mass index. And, more importantly, if you take host genetics and microbes together, you start to see a fuller picture of how life varies and changes over time.
Microbes are the base of the biosphere. They outnumber the stars in the universe by orders of magnitude and have been here for four billion years. There are more bacteria in your mouth than there are people on the planet. Every host organism lives in contact and association with microbes, and those microbes can cause variation in traits, whether it’s chronic disease, agricultural output, biodiversity loss or how thin we are — there’s a lot going on that microbes contribute to.
Q: Historically, the field of biology tends to categorize living things into taxa, the filing system for species, genus, family, order, etc. How does holobiont biology fit into or challenge that framework?
We envision that microbes are fundamental to how biologists explain variation in host life forms, for example animals and plants. So, in the case of classification of species, we’re making the case that organisms are not autonomous. They exist, by definition, always in association and in contact with microbes.
Just has been done with genetic engineering and selective breeding, we see this holistic way of thinking about life as an opportunity to harness the power of the microbiome to make improvements in agriculture and aquaculture, resilience in environmental sustainability, and advances in human health.
This holistic approach of holobiont biology will open the door to finding applications for live microbial communities that could, for example, make agriculture more resilient to climate change, help sustain biodiversity or improve human health by using microbes to combat chronic diseases including cancer, inflammatory bowel disease, cardiovascular disease, and diseases associated with aging.
Q: Essentially, you are saying that we should have a much broader view of what biology looks like, what evolution looks like, because there is an entire world on the microscopic level that is propelling life on the macro level. You reference ’Origin of Species’, Charles Darwin’s seminal work published in 1859, frequently in your paper. Why re-examine a 165-year-old book when introducing a new paradigm?
Darwin’s “Origin of Species” remains the bedrock of modern biology today. But it’s worth noting that the Origin of Species was written only about animals and plants. There were no bacteria in it. That doesn’t mean that Darwin’s principles do not apply to microbes, but he was focused on what he could see at the time. Now, we have a much fuller picture of the biosphere. What Darwin did was explain to us why forces of evolution shape lineages into new varieties and ultimately into new species, but he didn’t know the mechanisms that made these changes possible. He didn’t know about genetic mutations nor the microbial forces at work.
Q: You also address Mendelian genetics in the paper, the science of breeding for various traits as described by Gregor Mendel in the 1860s. There have been significant advancements in the study of genetics over the past century, from sequencing to editing, so how does the holobiont biology framework intersect with our modern understanding of genetic diversity and evolution?
During the 1920s to 1940s, biology had a revolution known as the Modern Synthesis, in which the 19th century discoveries of Mendel’s genetic laws merged with Darwin’s theory of evolution to create this beautiful explanation for how new variations of form and function develop. That science is what drove biology to where we are today.
Now, many scholars think we’re in a post-Modern Synthesis because we’re now adding microbiology into our understanding of host genetics and evolution. We’ve learned that microbes are also sources of new forms, functions, and variants of host life, just like genetic mutations. As a consequence, several operational and practical steps can be taken to infuse holobiont biology into the full fabric of the life sciences.
Q: How do you bring about this new paradigm shift in the life sciences?
It starts with how we define and teach biology. That means rethinking how we describe animals and plants; we’re not calling them animals and plants anymore. We’re thinking of animals and plants as a consortium of host and microbial cells that influence anatomy and physiology, because that is the reality of nature. We cannot think about animal or plant genomes in a way that’s separate from microbial genomes when we know that both genomic compartments are all part of the functional unit.
There is also a statistical, analytical aspect to what we’re going to see next. Just as we have databases to determine the influence of genetics on traits, we will need new analytics to determine the contribution of microbes and how they interact with genetics to explain traits.
Finally, once we have the databases and analytic tools developed, we can engineer microbes and microbiomes as much as we can engineer genes to make a better outcome for an organism, whether that’s in agriculture, the environment, or even for ourselves. Our hope is to use this concept to engineer a better future.
Other Penn State co-authors are Mónica Medina, professor of biology, and Nichole Ginnan, research project manager. Other authors on the paper are affiliated with the Center for Evolutionary Hologenomics at the University of Copenhagen, the Department of Natural History in Trondheim, Norway, the Università degli Studi Mediterranea di Reggio Calabria in Italy, the University of Padua in Italy, Aalborg University in Denmark, the Khalifa Center for Genetic Engineering and Biotechnology at the United Arab Emirates University, the Universidad Nacional de Colombia, Wayne State University School of Medicine, Clemson University, the University of Connecticut, Oregon State University and the University of Pittsburgh.
